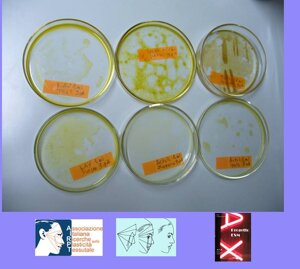

ISCRIZIONE AI CORSI AIRPT
ANTIAGING-ANTICANCEROGENESI
AB 53 RA
IL GOLD STANDARD PER L'ANTIAGING E L'ANTICANCEROGENESI CUTANEA
AB 53 RA è la sigla che designa una delle tecniche propedeutiche della CHIRURGIA COLLAGENOPOIETICA diretta a:
1. Rimuovere le cellule degenerate dermo-epidermiche
2. Attivare lo strato basale (cellule staminali)
3. Stimolare il microcircolo
AB 53 RA utilizza strumenti microchirurgici, disegnati e realizzati presso il nostro laboratorio allo scopo di operare su aree di diametro inferiore al millimetro e asportare strati cellulari successivi.
La tecnica non richiede, normalmente, l’uso di anestesia locale, perché utilizza le CRYOCAPS (sfere, capsule criogeniche), che producono anestesia topica in 10-20 secondi.
Qualunque area, danneggiata dai processi involutivi dell’invecchiamento cutaneo e dagli esordi di fenomeni degenerativi per-cancerosi, è da noi trattata con questo protocollo terapeutico, che utilizza una varietà di strumenti, secondo le differenti caratteristiche istologiche del tessuto.
Le tre azioni sinergiche realizzate da AB 53 RA producono:
1. Eliminazione delle neoformazioni
2. Levigatura cutanea
3. Viraggio del colorito cutaneo verso il rosa
4. Scomparsa delle aree iperpigmentate
5. Rimozione delle rughe superficiali
L’asportazione delle cellule cheratinizzate, degli strati superficiali dermici, delle scorie accumulate all'interno delle ghiandole sebacee e degli elementi cellulari degenerati apre la strada alla rigenerazione degli strati basali (cellule staminali) stimolati anche dalla vasodilatazione generata dal trattamento.
L’effetto immediato di ringiovanimento è prodotto dal cambiamento di colore dell’incarnato, che si uniforma perdendo, anche dopo un’unica seduta, le macchie (discromie), i segni prodotti dadepositi patologici cellulari, acquistando turgore e levigatezza immediatamente visibili.
COPYRIGHT © 2016 Associazione Italiana Ricerche sulla Plasticità Tessutale